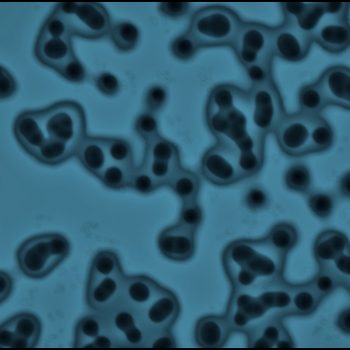

Welcome to the Social Art Award 2025 – Online Gallery!
We are grateful for the many powerful contributions from artists across the globe. The selected works reflect the diversity of contemporary social art practices and address urgent issues such as climate and water crises, social and economic inequality, migration, conflict, discrimination, and the protection of human and more-than-human life.
Below you will find the submissions from the edition of 2024/2025 that passed the initial jury round. The Online Gallery offers public visibility to these works and supports dialogue around their themes; it does not replace the final jury decision.
Thank you to all artists for sharing your inspiring and committed work. We invite you to explore the gallery and engage with the perspectives shaping the Social Art Award 2025.